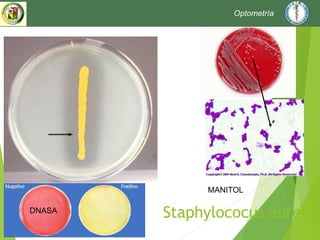
Staphylococus aureus
MANITOL
DNASA
Optometría

Este documento proporciona información sobre diferentes bacterias y sus características. Se describen géneros bacterianos como Staphylococcus, Streptococcus, Enterobacterias, Neisseria, Salmonella, Shigella, Clostridium, Pseudomonas y otros, detallando sus características de cultivo, pruebas, patologías asociadas y más. El documento también incluye información sobre hongos, parásitos y otros microorganismos.

![Agar Shigella Salmonella
Fermentadores de lactosa de los que no la fermentan, proporcionando buena inhibición de
coliformes sin restringir BGN patógenos.
Salmonella y Shigella (y otros no fermentadores de lactosa) producen colonias
transparentes, translúcidas, mientras los pocos fermentadores de lactosa que se desarrollan
dan colonias mucosas, rojizas.
Bacteria
Crecimiento Color de las colonias
Salmonella enteritidis bueno incolora
Shigella flexneri aceptable incolora
Proteus mirabilis regular incolora
Enterococcus faecalis escaso incolora
Enterobacter
aerogenes
regular crema/rosa
[Salmonella typhimurium]
Optometría](https://image.slidesharecdn.com/bact2017utm-170329120249/85/Bacterias-36-320.jpg)


























